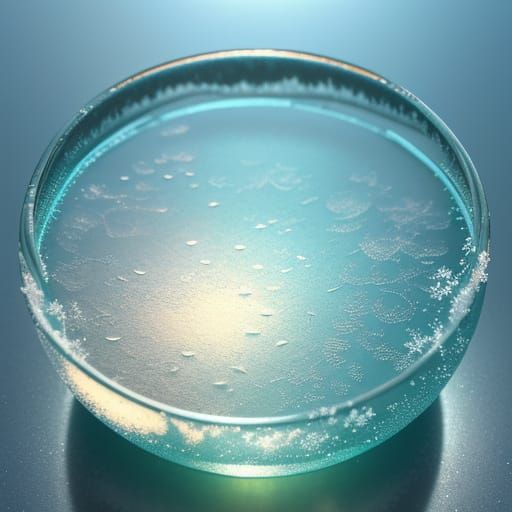
Engraved Yoto Glass in Serene Makoto Shinkai Anime Style

Create your own beautiful Japanese glass designs with our free AI image generator, easy to use and flexible.

Created 8 months ago · 0 comments· 0 likes
DreamShaper v8
This image captures a delicate, Makoto Shinkai-inspired scene of engraved yoto glass on a frozen surface, adorned with frosty bubbles and intricate patterns, bathed in soft pastel hues and serene natural light.
Created by Lourise on May 4, 2025 using the DreamShaper v8 AI image generator model.
Be the first to respond!
No comments yet.
Anime
Thumb
1:1
Short
50%
DDIM
